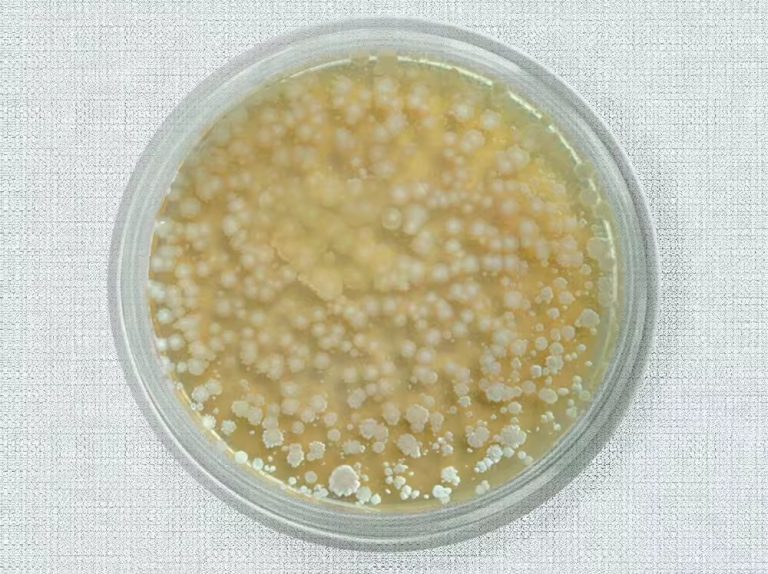
Research Direction of Bacillus Licheniformis 5 2025102307472188
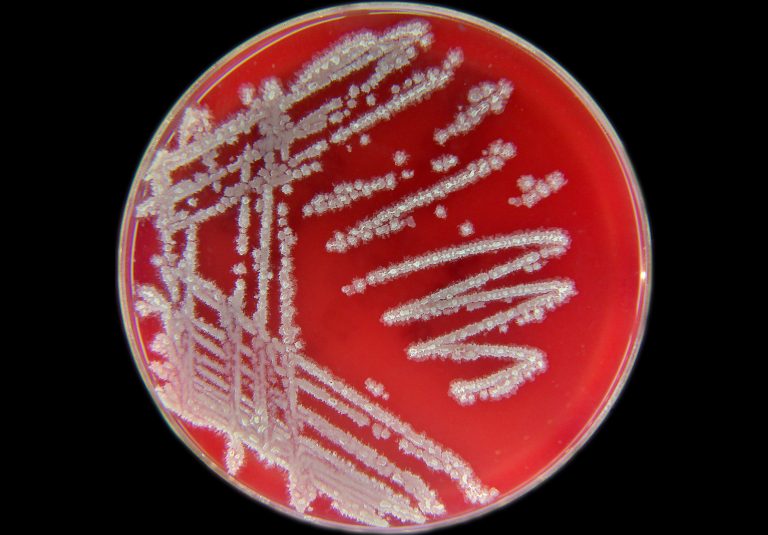
Pharmacological Action of Bacillus Licheniformis 6 2025102307450952

Characteristics of Bacillus Subtilis
Bacillus subtilis is a Gram-positive, rod-shaped, facultatively anaerobic bacterium commonly found in soil and the gastrointestinal tracts of humans and animals. Below are its key characteristics: Morphology & Structure: Physiological & Metabolic Traits: Environmental Role: Industrial & Biotechnological Uses: Would…